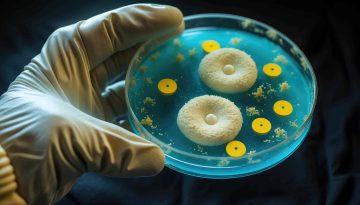
Amoxicillina a cosa serve: usi, dosaggi e indicazioni mediche
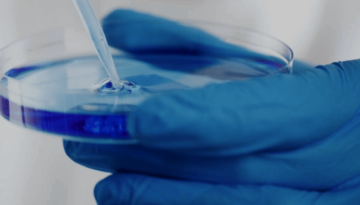
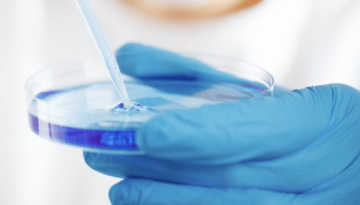

Farmaci da banco: guida a un uso consapevole
Entrare in farmacia o navigare sul web per trovare una soluzione rapida a un piccolo

Entrare in farmacia o navigare sul web per trovare una soluzione rapida a un piccolo

Ogni anno circa 120 mila italiani vengono colpiti da un infarto, grave situazione che si

Nel mondo circa il 20% della popolazione si ritrova a fare i conti con l’allergia

Tutti russano, chi più, chi meno, ma è una cosa piuttosto comune che capita quando

Molte donne notano un aumento di peso durante la menopausa. Cambiamenti ormonali, metabolismo più lento

Siamo ufficialmente entrati nell’epoca dell’alimentazione consapevole, e ci siamo da un po’. Mangiare sano è

Di tutti i malanni di stagione il raffreddore è senza ombra di dubbio quello più

La verdura è un alleato essenziale per la salute: ricca di fibre, vitamine e minerali, aiuta a prevenire molte malattie e migliora il benessere generale.

Molti di noi hanno farmaci in casa che si non usano più. Spesso la scadenza

Con l’avanzare dell’età l’equilibrio diventa sempre più precario: proprio per questo, abbiamo pensato a 10

Le contratture muscolari sono molto comuni in età avanzata. Possono causare dolore, rigidità e limitare

Il fosforo è uno dei minerali più importanti e abbondanti del nostro corpo. Come il

La Legge 104/1992 è un pilastro nell’assistenza delle persone con disabilità grave e nell’aiuto ai

Scopri quali medicinali portare in valigia per viaggiare sereni e preparati: cosa non deve mancare e cosa è meglio lasciare a casa

Scopri quali alimenti possono peggiorare l’artrite e aumentare infiammazione e dolore articolare. Una guida chiara per capire cosa evitare e come migliorare il benessere delle articolazioni

Scopri i benefici di una dieta a basso indice glicemico: mantieni stabile la glicemia, controlla il peso e previeni le malattie metaboliche scegliendo gli alimenti giusti ogni giorno

Scopri quali sono le malattie sessualmente trasmissibili più comuni in età matura e come prevenirle. Informazioni utili e consigli per proteggere la salute in modo consapevole

Scopri perché frutta e verdura sono indispensabili per una dieta sana ed equilibrata. Ricche di vitamine, fibre e antiossidanti, sono la base del benessere e della prevenzione quotidiana

Scopri perché lo stomaco può gonfiarsi nella parte alta e come alleviare il fastidio. Consigli su alimentazione, stile di vita e buone abitudini per ritrovare leggerezza e benessere

Scopri la piramide di Maslow e il suo significato nella psicologia moderna. Una guida per comprendere i bisogni umani fondamentali e come soddisfarli per raggiungere il benessere

Negli ultimi mesi è diventato un argomento cliccatissimo e sono tanti i contenuti social pubblicati

La glossopirosi, conosciuta anche come sindrome della bocca che brucia, è un disturbo fastidioso che

Cos’è il ticket sanitario e come funziona: chi paga, chi è esente e per quali prestazioni. Guida chiara al SSN con importi, esenzioni e come richiederle

Perché masticare lentamente fa bene alla salute: migliora la digestione, favorisce il controllo del peso e contribuisce al benessere generale. Ecco quanto tempo dedicare a ogni boccone

Scopri i benefici dell’acido azelaico per la pelle dopo i 50 anni: uniforma il colorito, riduce le macchie e migliora elasticità e luminosità senza irritare.

La protesi al ginocchio è uno degli interventi più eseguiti in ortopedia. Serve a migliorare

La tiroide è una piccola ghiandola a forma di farfalla, situata alla base del collo.

Le paure sono del tutto normali, ma a volte alcune possono essere più strane del solito. Proprio per questo, oggi abbiamo pensato di parlare di quella connessa ai buchi. La definizione corretta per questa paura è tripofobia. Scopriamo insieme cos’è e come trattarla!

Come riconoscere e gestire lo stress: dai sintomi fisici e psicologici agli strumenti pratici per ritrovare equilibrio, benessere e serenità nella vita quotidiana

Scopri come contrastare le macchie scure e mantenere la pelle luminosa e uniforme con l’avanzare degli anni. Consigli su creme efficaci e strategie per una pelle più elastica e idratata

L’autunno è appena cominciato, ma i tipici malanni stagionali sono già alle porte: per affrontare

Scopri come riconoscere e prevenire l’allergia al nichel. Guida pratica su cibi e oggetti da evitare per ridurre irritazioni e fastidi causati da questo metallo

Rivolgersi a uno psicologo è un gesto di coraggio e cura di sé. Scopri come la terapia può aiutare ad affrontare difficoltà emotive, traumi, lutti e migliorare il benessere personale

Scopri tutto sulla sepsi: cos’è, quali sono i sintomi e le possibili cure. Informarsi è fondamentale per riconoscere e affrontare tempestivamente questa rara infezione

Nuance Audio è un dispositivo acustico invisibile integrato in un paio di occhiali da vista.
Amplifica i suoni con chiarezza, riduce il rumore di fondo e ti aiuta a rientrare nelle conversazioni senza auricolari o dispositivi visibili. Tutto il comfort, tutto lo stile.

Con l’avanzare dell’età si possono avvertire dei dolori localizzati nelle articolazioni. Questi possono essere molto

I lividi possono comparire in diverse zone del corpo in seguito a una botta, ma

Scopri il ruolo della carnitina nell’aumentare energia e vitalità. Approfondisci cos’è, possibili controindicazioni e gli alimenti che aiutano a mantenere livelli ottimali per affrontare la giornata con più energia
Scopri a cosa serve l’amoxicillina, come usarla correttamente e quali dosaggi seguire. Tutte le indicazioni mediche essenziali per assumere questo antibiotico in sicurezza sotto controllo medico

Alimentazione e cervello: scopri i cibi che aiutano a prevenire declino cognitivo, demenza e Alzheimer, mantenendo la mente attiva e in salute con l’età

West Nile in Italia: cos’è il virus del Nilo occidentale, quali sintomi provoca e come proteggersi da questa infezione sempre più diffusa

Come riconoscere un neo pericoloso: segnali da non ignorare, campanelli d’allarme e consigli per un autoesame della pelle utile alla prevenzione

Mirtilli: proprietà, benefici e varietà di questo frutto estivo ricco di antiossidanti e vitamine. Scopri come usarlo in cucina e le possibili controindicazioni.

Quando si parla di super food non si può fare a meno di selezionare degli alimenti che, spesso, non sono poi così comuni per la nostra dieta.
Oggi abbiamo deciso di presentarti uno di questi: si tratta dei semi di chia. Scopri insieme a noi quali sono i benefici e come usarli in cucina.

Scopri come ripristinare l’equilibrio del microbiota intestinale dopo un malessere con alimentazione, probiotici e buone abitudini quotidiane

Glicemia dopo i 60 anni: scopri quali sono i valori normali, quando preoccuparsi e perché è importante monitorarla per la salute

Piante che assorbono umidità: scopri quali scegliere per il bagno e come aiutano a migliorare il benessere in casa in modo naturale, senza deumidificatore.

Cortisolo alto? Scopri cos’è, i sintomi e 7 modi naturali per abbassare l’ormone dello stress e ritrovare equilibrio, energia e benessere

Invecchiamento delle unghie: cause, segni e consigli per rallentarlo. Scopri come mantenere unghie sane e forti anche con l’avanzare dell’età.

Riflessologia plantare: cos’è, a cosa serve e quali benefici offre. Scopri come questa tecnica agisce sul corpo attraverso punti specifici del piede

Trascorrere l’estate al mare è molto comune per tanti italiani e, a volte, quando si

Dopo i 50 anni la frutta estiva diventa un alleato di benessere: scopri 10 frutti ricchi di acqua, vitamine e antiossidanti per idratarti e proteggere cuore, ossa e pelle

Con l’arrivo di agosto l’estate raggiunge il suo apice e il conto alla rovescia alle

Metodo 6 a 1: come fare una spesa sana e risparmiare senza rinunce. Scopri il metodo 6 a 1: la regola semplice per riempire il carrello di cibi sani, evitare acquisti inutili e risparmiare davvero sulla spesa.

Prendendoci cura della nostra salute orale non significa solo sfoggiare un sorriso perfetto: scopriamo insieme

L’acido folico ha un ruolo di primo piano nell’aiutarci a prenderci cura del nostro benessere:

Con l’estate tornano le alte temperature e, con esse, anche i disturbi legati alla pressione arteriosa bassa. Un fenomeno tutt’altro che raro, che può causare sintomi spiacevoli e, nei casi più estremi, anche malori veri e propri. Ma perché il caldo influisce tanto sulla pressione? E cosa possiamo fare per proteggerci?

Scopri perché l’estate ci rende più stanchi e affaticati. Caldo, umidità e afa influenzano il nostro corpo, trasformando le giornate estive in una vera sfida per le energie. In questo articolo, esploriamo le cause della stanchezza estiva e come affrontarla

Estate è sinonimo di sole, relax, vacanze, momenti spensierati, gite fuori porta, divertimento con gli

Disciplina millenaria, lo Yoga racchiude benefici incredibili tanto per il corpo quanto per la mente,

Stagione del cuore per tantissime persone, l’estate è finalmente arrivata, portando sole, giornate passate all’aria

Le infezioni urologiche sono disturbi fastidiosi e ricorrenti, che colpiscono le vie urinarie e possono

Quando si parla di zeolite, non si può fare a meno di menzionare quegli integratori

L’acqua è vita, dato che il nostro corpo n’è composto in buona parte. Questo elemento

Forse se ne sente parlare più in relazione alle donne, ma il pavimento pelvico è

Con l’arrivo della primavera, le punture di insetto diventano un fastidio piuttosto comune. Zanzare, api,

Scopri come funziona la telemedicina, quali vantaggi offre per la salute e come sta rivoluzionando l’accesso alle cure mediche. Tutto quello che devi sapere in un approfondimento chiaro e completo

Secondo i dati più dell’8% degli uomini sperimenta almeno una volta nella vita l’infiammazione alla

Quando si parla di salute le vitamine ricoprono un ruolo fondamentale, agendo su più fronti

Qualunque tipo di cute deve essere trattato in maniera attenta, giacché ha delle esigenze precise.

Scegliere un antinfiammatorio naturale come alternativa ai farmaci classici è una decisione che conquista ogni

Tra gli elementi essenziali per il corretto funzionamento del nostro organismo, il ferro occupa un

Il ginocchio gonfio e dolorante è un disturbo molto comune. Può colpire persone di tutte

L’ematocrito è un parametro che indica la percentuale di globuli rossi presenti nel sangue. Un

L’artrosi è una patologia cronica che colpisce le articolazioni: provoca dolore, rigidità e difficoltà nei

La sindrome di Gilbert è una condizione genetica benigna che interessa il fegato. È piuttosto

Trattare correttamente la pelle del volto significa selezionare accuratamente i cosmetici che si applicano ogni

La creatina (dal termine greco krèas, che significa carne) è una sostanza di origine aminoacidica,deriva

L’alimentazione è uno dei pilastri alla base del nostro benessere quotidiano: vediamo insieme quali cibi

Avete sentito parlare di stomia, ma non vi ricordate esattamente di che cosa si tratta?


Il trattamento dei capelli è fondamentale per avere una chioma sempre bella, luminosa e sana:

Quante volte vi è capitato di sentirvi sotto stress? Spesso anche con l’avanzare dell’età può

Il corretto funzionamento dell’apparato digerente è fondamentale per il benessere del nostro organismo e dipende

Si formano all’interno dell’occhio, nella parte del vitreo, e si presentano come corpi mobili puntiformi

La sindrome di Sjögren è una malattia autoimmune cronica caratterizzata soprattutto da secchezza orale e

Tra i frutti di bosco più apprezzati, il lampone occupa sicuramente il primo posto. Succoso,

Non è necessario diventare atleti provetti, basterebbe muoversi almeno un’ora al giorno. I rischi legati alla sedentarietà ci sono, ma ci sono soluzioni efficaci per non andarvi incontro.

La protesi peniena è una soluzione chirurgica utilizzata per trattare la disfunzione erettile grave, che

La ginnastica dolce posturale è un tipo di attività fisica che si adatta perfettamente agli

Parlare della forma e della consistenza delle feci è del tutto normale: i diversi tipi di feci ci consentono di conoscere lo stato di salute dell’organismo. Scoprite insieme a noi quali tipi di feci esistono e che cosa possono rivelare circa il nostro stato di salute.

Con l’espressione infezioni respiratorie si fa riferimento a processi infettivi che interessano gli organi che

Spesso quando si parla di cortisone ci si riferisce a un farmaco che viene utilizzato per il trattamento in una terapia. Questo elemento può lasciare degli effetti indesiderati sull’organismo come, per esempio, il gonfiore o la ritenzione idrica. Oggi ti diamo alcuni suggerimenti per capire come smaltire velocemente il cortisone nel modo corretto

La pizza è uno dei simboli per eccellenza della nostra cucina e non manca quasi mai nella dieta degli italiani. Ma mangiare la pizza la sera fa ingrassare? Oggi rispondiamo a uno di quei quesiti che tante persone si fanno quando portano in tavola un cartone di pizza!

Con l’avanzare dell’età è normale notare un’accentuazione dei difetti posturali. Ecco perché crediamo che sia importante svolgere determinate attività fisiche per cercare di porre rimedio. Qui di seguito vi diciamo come migliorare i difetti di postura dovuti all’età.

È imprescindibile per la vita, si distingue per il suo colore rosso e il suo

Approfondiamo di seguito che cos’è nel dettaglio il declino cognitivo, le sue cause, i sintomi principali e altri aspetti utili da sapere.

Come forse molte persone già sanno, l’acido urico è una sostanza di scarto prodotta in

Allenarsi non significa solo ed esclusivamente iscriversi in palestra. Allenarsi significa semplicemente prendersi cura di

Affrontare un intervento chirurgico è un evento che può destare preoccupazione e provocare anche una

Il polipo uterino è una condizione comune che colpisce molte donne, spesso senza che queste

Con l’avanzare del tempo la necessità di tonificare il corpo si fa più forte: se voleste provare degli esercizi per rassodare i glutei superati i 55 anni, vi suggeriamo di provare questi 5.

Un recente studio apparso sulla rivista scientifica “Nature”, condotto sui topi, ha sottolineato perché mangiare

Approfondiamo di seguito i sintomi che possono manifestarsi in caso di eosinofili alti, le cause di questa condizione, quando preoccuparsi e come intervenire.

Approfondiamo di seguito nel dettaglio le cause e i sintomi associati al dolore alle gambe e quali rimedi mettere in campo per alleviare il malessere.

Approfondiamo di seguito nel dettaglio in cosa consiste, cosa comporta e altri aspetti da tenere in considerazione.

Scopriamo di seguito in cosa consiste questa disciplina, tutti i suoi benefici e altri aspetti utili da tenere in considerazione.

n questo articolo esploreremo i sintomi, le cause e le cure disponibili per affrontare efficacemente il virus intestinale, come prevenirlo e quando rivolgersi ad un medico.

Il battito cardiaco, o frequenza cardiaca, è un indicatore chiave della salute del cuore. Monitorarlo

La combinazione di allenamento cardio e sollevamento pesi è una strategia efficace per migliorare il
L’influenza 2025 sta letteralmente mettendo ko tutta l’Italia in modo più o meno intenso. Il

Esistono molti modi per prevenirli o alleviarli, mantenendo così una vita attiva e indipendente. In questo articolo esploreremo i consigli più utili e i rimedi pratici per prevenire i dolori articolari in età avanzata.

L’intervento alla cataratta viene eseguito in breve tempo e senza pernottamento in ospedale: scopriamo di seguito come funziona e altri dettagli utili sul post intervento per una ripresa ottimale.

Sono diverse le problematiche che possono colpire gli occhi, tra cui infiammazioni da trattare prontamente: di seguito approfondiamo quali sono le più comuni, le loro cause, i sintomi e i rimedi con cui contrastarle.

Alla base di una vita sana il movimento è un pilastro immancabile a qualsiasi età.

Oltre ai tanti benefici sul corpo, praticare regolarmente un’attività fisica è un toccasana per la mente, che consente di percepire subito più energia, riducendo i livelli di stress, aumentando la memoria e tenendo alla larga

Serve costanza, tanta forza e, nella maggior parte dei casi, un supporto psicologico. Non importa quanto tempo si impiegherà, l’importante è arrivare in fondo e, finalmente, dire addio al fumo.

Diversi studi hanno riportato che questo alimento ha effetti favorevoli sulla salute delle persone. Qui scopriremo quali, così da sfatare ogni mito: il cioccolato fondente fa bene alla salute.

La stagione fredda è il momento perfetto per rilassarci e prenderci cura del nostro benessere: ecco quali sono le migliori SPA in Italia dove possiamo concederci del tempo per noi stessi.

Di seguito, scopriamo nel dettaglio qual è la dieta più efficace per perdere peso in modo duraturo e altri consigli utili per dire addio ai kg di troppo in modo facile.
La presenza di macchie rosse sulla pelle è una manifestazione cutanea piuttosto comune, ma come

Per vivere una vita sana e longeva è imprescindibile prendersi cura della salute e, pertanto,

Qui scopriremo i 5 esercizi più efficaci per ritrovare la giusta energia e tornare a guardarsi allo specchio con un occhio più amorevole: il benessere fisico non tarderà ad arrivare!

Un’alimentazione ricca e varia, dove non mancano anche i legumi, consente di godere di diversi benefici. Scopriamo 10 benefici dei legumi per gli over 55 e non solo.

Spesso sentiamo dire che il consumo delle mandorle è consigliato per i benefici, i nutrienti che contengono e l’effetto afrodisiaco: scopriamo i miti e le verità di questa frutta secca.

Approfondiamo di seguito cause e sintomi della sindrome metabolica e come trattarla e prevenirla dopo i 60 anni.

Toccasana per la salute, questo ortaggio è chiamato scientificamente Cynara cardunculus: cugino del carciofo, cos’è, proprietà e benefici sulla salute

Approfondiamo in questo articolo cause e sintomi dell’artrite reumatoide e come alleviare i dolori che provoca.

Tra le spezie più antiche e conosciute in assoluto spicca la cannella, nota per il

Quando l’inverno arriva e le temperature iniziano a scendere, proteggere la pelle di viso e

Gli interventi di prevenzione si suddividono in tre categorie: primaria, secondaria e terziaria e tutte e tre sono importanti, se non indispensabili scoprili tutti

Con l’avanzare dell’età, poi, queste malattie possono aumentare: quali sono le più comuni che colpiscono gli over 55? E come si trattano?

La carenza di ferro è una delle condizioni nutrizionali più prevalenti e sottovalutate che affligge

La televisita è un atto sanitario in cui medico e paziente, eventualmente supportato da un caregiver, interagiscono a distanza e in tempo reale: durante il servizio, oltre alle diagnosi ed eventuali chiarimenti sulle terapie, possono essere anche prescritti farmaci e cure

Un’alimentazione sana, equilibrata e varia è una preziosa alleata per rallentare l’invecchiamento e sentirci in

Proprio per questo, è importante capire come mantenere la forma fisica senza andare in palestra dopo i 60 anni. In questa maniera, ci si potrà sentire sempre bene e affrontare le giornate al meglio!

Il consumo di determinati alimenti per il nostro organismo è davvero importante, poiché ci permette

Scopriamo di seguito quali sono i disturbi della tiroide e come si curano, focalizzandoci sugli over 60.

I sintomi, le cause e i rimedi alla pressione alta La pressione alta (o ipertensione

Con le giuste azioni si può correre ai ripari migliorando la mobilità muscolare: lo stretching viene in nostro aiuto per raggiungere questo scopo

Scopriamo di seguito come prevenire l’influenza, approfondendo una serie di consigli utili e rimedi naturali.

Che cosa sono i cibi alcalini, quali quelli acidi, in che cosa consiste la “dieta alcalina” e quali sono i benefici principali

Un viaggio alla scoperta dei benefici e controindicazioni dei peperoncini piccanti. Con una lista dei più piccanti

Da sempre utilizzato in cucina, lo zenzero è diventato popolare negli ultimi anni nel vasto

Sport completo in cui viene coinvolto tutto il corpo, il nuoto è una disciplina tra

La pelle cambia naturalmente con il tempo, ma i segni dell’invecchiamento non devono diventare un

Gli sbalzi di umore e l’irritabilità possono rovinare la quotidianità: ecco che cosa si può fare per conviverci.

Chiunque, nella propria vita, desidera migliorare la propria memoria per potersi ricordare momenti della giornata

La salute dei nostri reni può essere analizzata dalla pipì e, in particolare, dal peso

La menopausa è una tappa naturale ma spesso complessa nella vita di una donna. Questo

Adottare le migliori tecniche di meditazione per combattere l’ansia e lo stress quotidiano può essere

Che cos’è la crisi di mezza età e che cosa comporta nell’uomo? Ci sono dei

Muoversi, mantenendosi costantemente allenati, fa davvero bene allo spirito e al corpo: ecco perché tutti

L’allenamento con la kettlebell è una delle modalità più efficaci e versatili per migliorare la

Contraddistinto dal suo colore rosso inconfondibile, il melograno racchiude talmente tanti benefici da rientrare nella

Per invecchiare nel migliore dei modi, dobbiamo tenere d’occhio le ossa: scopriamo insieme come possiamo

Il doppio mento è un’imperfezione che può davvero rovinare l’aspetto del nostro viso: scopriamo insieme

Portare in tavola alimenti di ogni genere è importante per avere una dieta sana e

Prendersi cura della propria salute è fondamentale e se vi piacerà approfittare delle cure terminali

Per tenere sotto controllo il colesterolo è fondamentale adottare uno stile di vita sano, curare

L’omocisteina alta è una problematica meno rara di quanto si pensi e non va assolutamente

La cipolla di Tropea è uno di quei prodotti che si trovano facilmente ai banchi

Perdere i capelli è del tutto naturale, ma vi sono anche dei casi particolari in

Lo sport, e l’attività fisica in generale, contribuiscono a mantenerci in buona forma anche dopo

Spesso gli avvenimenti della giornata possono metterci in uno stato d’ansia o di agitazione, costringendoci

Spesso sottovalutati e poco raccontati, i problemi alla tiroide nell’uomo sono tutt’altro che rari. Prima

Un buon percorso di dimagrimento richiede un occhio di riguardo per le nostre abitudini alimentari:

Il grasso viscerale è messo in relazione con parecchie problematiche che possono riguardare la nostra

I dolori intercostali possono avere molteplici cause e manifestarsi in momenti differenti: ecco come possiamo

strategie per affrontare gli attacchi di panico e ritrovare la calma e la serenità.

Ecco i rimedi naturali per gestire il problema della stitichezza in modo delicato e senza effetti collaterali.

Cerchiamo di fare ordine in questo marasma, focalizzando la nostra attenzione sugli aspetti più importanti che riguardano la vitamina D3.

Scoprite insieme a noi i benefici e le proprietà afrodisiache del frutto della passione

Problemi di zanzare? Le piante carnivore sono una soluzione naturale ed efficace per controllare la popolazione di zanzare.

Percorso Kneipp: cos’è, come funziona e quali sono i benefici Il percorso Kneipp è una

Gli anni passano e, come è normale che sia, il corpo cambia. L’avanzare dell’età incide

Vediamo insieme cosa determina la ptosi palpebrale, i sintomi con cui si presenta e i rimedi per contrastarla e attenuarne l’effetto

Ogni donna dovrebbe praticare l’autopalpazione del seno per tenere sotto controllo i seni ed identificare

Soggetti a continui sfregamenti e attriti, i piedi e le mani sono un terreno fertile per i calli. Come toglierli naturalmente

Lo yoga non è solo una pratica antica con radici spirituali profonde, ma è anche un’attività estremamente versatile che si adatta a diverse esigenze e obiettivi, compresa la perdita di peso

Con il passare degli anni, le articolazioni possono irrigidirsi a causa del loro invecchiamento e

Sebbene spesso associata all’invecchiamento, la stempiatura può iniziare già in età giovanile a causa di fattori genetici, ormonali e ambientali.
Esistono tuttavia alcuni modi per trattare la stempiatura.

Fare l’amore è una componente fondamentale della vita umana: sappiamo quanto influenzi positivamente non solo la sfera emotiva ma anche quella fisica.

capelli possono diventare fragili, secchi e crespi a causa di vari fattori coem l’invecchiamento. Ecco come mantenerli sani con collagene e cheratina

Conosci la vespa velutina? È nota anche come calabrone asiatico, un insetto invasivo che negli ultimi anni ha suscitato preoccupazione in Europa…

La respirazione diaframmatica è una tecnica di respirazione profonda che coinvolge il diaframma, il grande muscolo situato alla base dei polmoni.

Mantenere o aumentare la massa muscolare dopo i 60 anni è fondamentale per la salute e per mantenersi autonomi nelle attività quotidiane

Che cosa fare in caso di una scottatura solare della pelle dopo i 50 anni? Scoprite con noi come trattare la cute in caso di un’esposizione solare eccessiva!

Non vedete l’ora di sfoggiare i vostri outfit estivi, ma le vostre braccia a tendina

Come preparare la pelle matura per affrontare i danni dell’esposizione solare con Gold Collagen

L’amore può assumere tante sfumature, ma quando questo sentimento non è corrisposto, può suscitare in

Possiamo cercare di mantenere bella fresca ed efficace la nostra memoria con alcuni simpatici esercizi e giochi da svolgere ogni giorno.

Per vivere in modo rilassato e coinvolgente i piaceri dell’eros, vi suggeriamo 5 metodi infallibili che vi aiutano a ritardare davvero l’eiaculazione:

Per idratarsi e combattere al meglio il caldo è necessario mangiare bene in tavola: ecco

Gli esami del sangue sono utili anche per tenere d’occhio il benessere della prostata: i valori PSA, che cambiano in modo importante a seconda dell’età, sono un primo utile indicatore a nostra disposizione

Da tempi immemorabili, l’umanità ha cercato il segreto della longevità, desiderando prolungare la propria vita. Oggi, più che mai, il tema della longevità è molto discusso.

Che cosa rende così straordinario l’avocado? Scoprite con noi quali sono le proprietà e i benefici più interessanti di questa drupa per gli over 50

Come avere un’erezione forte: i 10 migliori cibi per durare di più

Le ciliegie sono uno dei frutti più amati dell’estate, non solo per il loro sapore dolce e succoso, ma anche per le loro numerose proprietà benefiche.

Quando si ha a che fare con problemi di digestione e con il colon irritabile non si può fare a meno di cercare degli alimenti sicuri per la propria dieta. Proprio per questo, abbiamo pensato di offrirvi una lista dei cibi sicuri

Il Nordic walking, noto anche come camminata nordica o camminata sportiva, è una disciplina fitness che sta guadagnando sempre più popolarità, soprattutto tra gli over 50.

Chi l’ha detto che l’eros è solo cosa per i giovani? Scoprite subito come fare del buon sesso dopo i 50 anni sia un toccasana per il benessere psicofisico

Con l’avanzare degli anni, diventa un po’ più difficile mantenersi in forma: scoprire quali sono

Affrontare i dolori articolari richiede una comprensione approfondita delle loro cause e dei trattamenti più efficaci.

Con l’arrivo delle prime giornate di primavera, molti iniziano già a correre con la mente

Gli asparagi sono un ortaggio primaverile ricco di proprietà benefiche e dal sapore delicato, elementi ideali per una dieta sana e bilanciata. Scopri quali

Jet lag o il travel fatigue è un disturbo che tutti, almeno una volta, hanno

Si tratta di un assegno di assistenza mensile rivolto a persone over 80: che cos’è il bonus anziani da 850 euro e come funziona? Cerchiamo di fare chiarezza.

Rappresenta la fase immediatamente successiva all’orgasmo: il periodo refrattario è per l’uomo una specie di

Scolpire il fisico per una donna o evitare il decadimento dopo i 50 anni per un uomo è importante per il proprio benessere. Scoprite perché dovreste scegliere il pilates come miglior sport quando si passano i cinquant’anni.

Si afferma spesso che la prevenzione è la miglior cura: ecco perché è importante sapere quali sono i valori normali della glicemia per le persone over 50 (ma anche di altre fasce di età)

Lo stile di vita, l’alimentazione e l’attività fisica ci aiutano a mantenerci in buona forma:

È vero che superati i 50 anni i rapporti sessuali diminuiscono? Uomini e donne fanno

I benefici delle camminate per l’organismo sono molteplici: scoprite come potete trarre il meglio da questa attività fisica che è ideale per il benessere personale a tutte le età.

Come scegliere le scarpe da trekking da donna. Per chi si lancia alla conquista di una vetta, le scarpe rappresentano una componente fondamentale

La disfunzione erettile è un disturbo che colpisce il genere maschile dal punto di vista della sfera sessuale. Consiste nell’incapacità di mantenere un’erezione che sia soddisfacente, crea non poco disagio negli uomini. Vediamo insieme le cause, i sintomi, i rimedi

“Povertà di muscolo”: l’etimologia parla chiaro. La sarcopenia è dunque un sinonimo di invecchiamento, il

Chi è esente dal pagamento del ticket? Che cosa comporta l’esenzione dal ticket? Queste sono solo due delle tante domande riguardo al tema in questione. Andiamo a vedere più nel dettaglio tutto ciò che riguarda l’argomento e che cosa prevede x tutti coloro con età superiore a 65 anni: requisiti, forme di esenzione e obiettivi.

Scoprite come iniziare a correre a 50 anni: l’esercizio fisico, insieme con l’alimentazione e lo stile di vita sano, è uno degli alleati per continuare a sentirci in forma ogni giorno.

Con l’arrivo della menopausa spesso sentiamo parlare di secchezza vaginale, ed è vero, ma altrettanto

Ogni situazione richiede la giusta analisi, quindi cerchiamo di vedere insieme quali sono le cause più comuni e soprattutto che cosa fare per farli passare e tornare a stare bene.

Il cambiamento che la menopausa provoca nel corpo e nella mente di una donna è piuttosto significativo. Ecco come fare eccitare una donna in menopausa

Particolare tipologia di massaggio, il linfodrenaggio è molto amato, specialmente dalle donne. Tecnica manuale volta

Alimentazione e attività fisica sono i migliori alleati contro il colesterolo. Se soffrite di colesterolo alto e non sapete da dove cominciare per abbassarlo, sappiate che la dieta è fondamentale.

L’autoerotismo fa bene alle donne, anche in menopausa. I benefici che se ne possono trarre sono infatti numerosi e benché per molte donne sia ancora un grande tabù parlarne, la masturbazione è a tutti gli effetti una pratica assolutamente positiva per il benessere psico-fisico.

Come uscire dalla depressione superati i 50 anni e tornare a vivere. La depressione in realtà è un disturbo molto comune. Pare infatti che nel mondo almeno 5 persone su 100 siano depresse

Una condizione comune negli uomini di età superiore ai 50 anni è la cosiddetta prostata

La dieta migliore per perdere peso in menopausa naturalmente senza sforzi e privazioni. Ricca di alimenti nutrienti come frutta, verdura, proteine magre e cereali integrali.

Ormone steroideo presente sia negli uomini, sia nelle donne, il testosterone è però considerato il

Pianta sempreverde originaria dell’India, l’ashwagandha è utilizzata in campo ayurvedico ed erboristico: quali sono le sue proprietà?

Il colesterolo è una delle tante sostanze presenti nel nostro organismo. Quando i suoi valori

Il mal di pancia molto spesso colpisce all’improvviso. È capitato quasi a tutti e a

Avere la pressione bassa è una condizione che molto spesso debilita. Tecnicamente chiamata ipotensione, la

La Domenica delle Palme è la domenica antecedente Pasqua ed è qui che i fedeli si recano in chiesa a benedire l’ulivo: qual è il significato?

Con il cambio di stagione le nostre difese immunitarie tendono ad abbassarsi. Rafforzarle, dunque, è doveroso: come fare?

I benefici delle mandorle sono numerosi. Consumate nelle giuste quantità porteranno solo benefici a mente e corpo

La stitichezza colpisce circa il 20% della popolazione, ma può essere combattuta grazie all’alimentazione: ecco 10 cibi per sentirsi meglio

Milan Longevity Summit. Dal 14 al 27 marzo, Milano ospita il più grande evento open sul tema della longevità. Siete tutti invitati! Partecipazione gratuita

Il mal di gola è un fastidio molto comune: bruciore, dolore, arrossamento e pizzicore. Quali sono i rimedi naturali per sconfiggerlo?

Consumare regolarmente frutta di stagione porta grossi benefici all’organismo (e all’ambiente), ma quali mangiare mese per mese?

Uno stile di vita sano è la chiave per vivere bene, su questo siamo tutti

Nel contesto della mobilità domestica, i montascale rappresentano una soluzione innovativa che offre indipendenza e accessibilità a

Che cos’è, perché controllare e come eliminare l’acido urico in eccesso velocemente e con rimedi naturali: la guida e i consigli pratici

Se c’è un piatto da non lasciarsi sfuggire, specialmente nella stagione invernale, è proprio la

Il gonfiore alle mani è un fenomeno molto più comune e molto più diffuso di

Se non si tratta di una situazione rischiosa è possibile ripristinare valori pressori normali intervenendo sullo stile di vita e sull’alimentazione. Vediamo che cosa è bene sapere

Cocooners presenta la guida per comprare i prodotti della parafarmacia online Farmasave. Scopri come fare nell’articolo.

Con il freddo gli anziani sono le persone più a rischio e per loro l’effetto “killer” del freddo è il doppio rispetto a quello del caldo

Tutto quello che è importante sapere su questa vitamina e su come intervenire nel caso in cui ci sia un deficit significativo della B12

Le transaminasi GPT (o ALT) sono enzimi essenziali per il corretto funzionamento del fegato: la

Che cos’è la pappa reale? Possiamo descriverla come una gelatina dalla consistenza semifluida, dal colore

Un minerale molto importante per la salute di denti, ossa e non solo. Dove lo si trova maggiormente? Quali sono i rari rischi da deficit? Qui trovate molte delle risposte

Nel corso della vita, gli uomini attraversano un periodo di cambiamenti fisici e psicologici noto

La menopausa è un capitolo inevitabile nella vita di una donna, un processo biologico che

Affrontare il dolore causato dall’infiammazione del nervo sciatico è spesso una sfida complessa, richiedendo un

Le placche in gola sono un disturbo molto comune che indica la presenza di processi

Virus influenzali e Covid 19 riducono la riserva di NAD+, la bio-molecola che presiede al nostro metabolismo: come reintegrarla e perché è così importante

Il gonfiore ai piedi è un problema molto comune e più diffuso di quanto si

“Una bella risata e un lungo sonno sono le migliori cure nel libro del medico”,

L’aspettativa di vita indica il numero di anni che rimangono da vivere ad una persona, all’interno di una popolazione, a partire da una certa età

(ADV – Contenuto sponsorizzato) Nel sempre più dinamico panorama della salute digitale, acquistare farmaci online

(ADV – Contenuto sponsorizzato) Cocooners è entusiasta di annunciare la sua collaborazione con Farmasave. Questa

Che cos’è l’osteoporosi e come si può contrastare e/o prevenire con uno stile di vita corretto? Tutto quello che c’è da sapere

Come intervenire in maniera naturale per mantenere attiva la memoria quando, dopo una certa età, inizia a fare un po’ cilecca. Ecco i nostri consigli sugli integratori migliori da assumere

Come intervenire in maniera naturale quando la prostata è infiammata sia con i rimedi verdi sia con la corretta alimentazione

Solo con la prevenzione si può conservare la salute degli occhi o trattare la malattia al suo esordio

(ADV – Contenuto sponsorizzato) Camminare con stile e comfort è un desiderio condiviso da

Lo sport rappresenta una valvola di sfogo e un modo per tenersi in forma per

I 50 anni costituiscono una tappa fondamentale del percorso, ma rappresentano anche un momento critico,

Secondo l’Organizzazione Mondiale della Sanità, le Cure Termali rappresentano una delle più antiche forme di

Molti lo ritengono impossibile e invece non lo è: si possono avere muscoli tonici anche a 50 anni e oltre. Ecco alcuni dei nostri consigli

Il 14 novembre è la Giornata mondiale del diabete, per ricordare il suo grande impatto sulla vita di moltissime persone e sul sistema sanitario

Parallelamente al progressivo e talvolta repentino cambiamento degli stili di vita, che ha allontanato le

Molti di voi le conosceranno già, ma se si vuole vivere più a lungo e soprattutto in salute, occorre prendersi cura di noi stessi a 360 gradi non dimenticando mai le pratiche necessarie a garantire un completo benessere al nostro organismo

Negli ultimi anni i ricercatori hanno sempre più lavorato sullo studio dei cosiddetti geni della longevità e sulla produzione di sirtuine, delle proteine necessarie a tutti gli esseri viventi e che hanno a che fare con l’allungamento della vita. Vediamo di capirne insieme un po’ di più

Il corpo umano somiglia a una macchina e ogni ingranaggio deve essere monitorato così come

Nel dicembre del 2020 il Ministero della Salute ha inserito la telemedicina tra le pratiche

Al giorno d’oggi è fondamentale prendere decisioni e adottare comportamenti che conducono a un maggiore

Che cosa può scatenare la glicemia alta? E che cosa fare per abbassarla subito? Come sempre la corretta alimentazione ci viene in aiuto. Vediamo quali cibi privilegiare e quali, invece, evitare

Dopo i 60 anni vi capita di dimenticare le cose? Non allarmatevi: questo fenomeno non sempre si riferisce a malattie serie.

Il colesterolo è un alcol appartenente alla famiglia degli steroli (complesse molecole solubili nei grassi),

La creatinina alta è un indicatore importante di un possibile malfunzionamento dei reni.
Quello che c’è da sapere per prevenire il rischio d’insufficienza renale cronica

Per la caduta dei capelli in menopausa ci sono diverse soluzioni naturali che possono aiutare a migliorare l’aspetto della vostra chioma

Quale è la differenza tra osteopenia e osteoporosi? Che cosa caratterizza l’osteopenia e come si può prevenire?

Che cosa sono, quali sono le possibili cause e come si manifestano. Tutto quello che c’è da sapere

Non è facile orientarsi nel campo di quelle che vengono definite demenze. La più nota è la malattia di Alzheimer. Vediamo come si distingue dalle altre e quali sono le caratteristiche specifiche della demenza e poi, più nello specifico, proprio dell’Alzheimer

La mancanza di sodio, meglio nota come iponatriemia, si verifica quando il corpo contiene poco

L’olio essenziale di rosmarino è un prodotto dalle molteplici proprietà e caratteristiche e per questo

L’alimentazione riveste un ruolo fondamentale per mantenere un buono stato di salute a qualsiasi età

L’osteoporosi è una patologia cronico-degenerativa associata a un progressivo aumento della fragilità ossea con aumento

Prima dell’arrivo della menopausa il nostro corpo inizia a mandarci dei segnali. È importante sapere che anche se si parla di sintomi la menopausa non è una malattia e non va demonizzata

Il nostro organismo ha la necessità di ripulirsi dalle scorie che accumula. Se il fegato non funziona a dovere questa funzione risulta compromessa con pericolose conseguenze. Ecco che cosa possiamo fare con l’alimentazione e con i rimedi verdi per dare l’avvio al processo di depurazione del fegato

A causa delle fluttuazioni ormonali, quando la menopausa è in arrivo possono manifestarsi dolori alle gambe. Vediamo di capirne le ragioni e come poterli prevenire

Come devono essere i valori normali di colesterolo in età adulta? Quali sono i fattori che possono determinare un innalzamento del colesterolo? A questa e ad altre domande rispondiamo qui

Il caldo può compromettere anche seriamente la nostra salute, per cui è necessario adottare dei comportamenti corretti per ridurne i rischi

Oltre alla tanto temuta ipertensione, un disturbo che può colpire gli over 60 (e non solo) è l’ipotensione, la pressione bassa. Il caldo può essere un fattore scatenante, ma anche il cambio repentino di posizione e, nei casi più seri, alcune condizioni cliniche. La buona notizia è che, se non ci sono patologie gravi all’origine, l’ipotensione si può risolvere rapidamente portando in tavola i cibi giusti

Da che cosa dipendono, come si manifestano e come porvi rimedio

Più che definire quanto debba essere il colesterolo in base all’età, è importante conoscere i valori di riferimento in base al profilo di rischio e che cosa fare, se occorre, per abbassare il colesterolo cattivo (LDL)

In estate o se si sta a lungo in piedi è facile che alla sera i piedi e le caviglie possano gonfiarsi.
Ci sono invece una serie di disturbi più seri che possono essere all’origine del problema. Facciamo insieme il punto

Una corretta alimentazione e uno stile di vita sano aiutano a star bene, a maggior

Quando l’età avanza è fondamentale prendersi cura della prostata, anche attraverso l’alimentazione. Le banane vantano

Ormai sappiamo con certezza che l’alimentazione giusta ha effetti benefici sull’organismo. Alcuni cibi hanno un vero e proprio effetto curativo. Qui, nello specifico, vediamo quelli dall’azione antinfiammatoria

Il traguardo dei 50 anni può spaventare molti uomini e altrettante donne perché il corpo

Anche se può sembrare inverosimile per la maggior parte delle persone, quello di un’alimentazione sana

La scelta di che cosa portare in tavola per mantenere il cervello e la memoria attivi va fatta con cura. Sono indubbiamente da privilegiare i cibi ricchi di acidi grassi Omega 3.
Vediamo meglio nel dettaglio quali alimenti privilegiare e perché

Come integrare le carenze di vitamine e antiossidanti in un periodo della vita in cui le cellule faticano a produrre in quantità

Per riuscire a far crescere i livelli di HDL occorre rivedere la propria alimentazione introducendo i cibi più adatti. Ecco i nostri consigli

Ecco i nostri suggerimenti per aumentare l’apporto di vitamina D attraverso il consumo di determinati cibi

La malattia cardiovascolare nelle donne rimane, ancora oggi, poco studiata, poco riconosciuta, sotto-diagnosticata e sotto-trattata.

Qual è la postura corretta e perché è importante mantenerla ne parliamone con il Prof. Riccardo Finco dell’Università Cattolica di Milano

Le cure naturali, l’alimentazione giusta e quella da evitare
per mantenere in salute l’apparato urinario maschile

Agire sulle proprie abitudini alimentari privilegiando cibi per loro natura in grado di abbassare la pressione è sempre la scelta giusta

Quando l’intestino è pigro, è necessario aiutarlo

All’incremento progressivo dell’aspettativa di vita media, un cambiamento positivo che si deve alle tante innovazioni

Come si verifica, da che cosa dipende e come remineralizzare l’organismo attraverso l’alimentazione

Le motivazioni per cui il potassio può abbassarsi e come ripristinare livelli normali intervenendo con la giusta alimentazione

Come intervenire con l’alimentazione giusta per diminuire l’infiammazione della prostata

Le malattie renali spesso si sviluppano in modo silenzioso, per cui è importante la prevenzione e la diagnosi precoce di queste patologie.

Se ne avete sentito parlare, ma non ne avete mai letto, è il momento per farlo

La camminata, soprattutto quella sportiva, non migliora solo la muscolatura delle gambe e dei glutei ma, se svolta correttamente, può essere un ottimo esercizio per rassodare le braccia ed eliminare quello spiacevole effetto a tendina

Le mani gonfie al mattino possono dipendere da svariati motivi, che vanno dalla semplice posizione errata durante la notte a problemi circolatori, articolari o altro. Scopriamo insieme le possibili cause e come intervenire

Se la prostata è ingrossata, o comunque si è in un’età a rischio d’ipertrofia prostatica, è buona norma evitare o limitare il più possibile tutti i cibi ad alto potere infiammatorio. Vediamo insieme quali

I benefici del bicarbonato di sodio vanno da rimedio naturale per acidità di stomaco, dolore muscolare, infezioni delle vie urinario e renali all’azione di pulizia e bellezza

Se fino all’età della menopausa nelle donne e negli uomini c’è una sensibile differenza su come debbano essere i valori pressori, dopo una certa età le differenze si assottigliano. Ecco quello che c’è da sapere

Il testosterone è un ormone importantissimo per la salute, non solo perché aumenta la libido,

La solitudine e la paura dell’invecchiamento possono essere contrastati spostando il punto di vista e aprendosi alle relazioni e alla voglia di concedersi nuove occasioni di socialità

Gennaio è il mese perfetto per abbracciare con maggior intensità la community di Cocooners. Siglando

La solitudine a 50 anni può fare più paura, perché avviene in una fase delicata della vita, ma, se ben gestita, può presentare molti aspetti positivi

Sono molti i modi per stare bene. Qui alcuni consigli

Altro che un peso, gli anziani possono essere delle risorse in ambito sociale, lavorativo ed economico, ma non vengono valorizzati

Per mantenere la nostra mente attiva un’ottima soluzione è rappresentata dal gioco. Ecco qui una nostra scelta di alcuni giochi che mantengono attivo il nostro cervello prevenendo il deterioramento cognitivo

Cosa fare quando si soffre di acidità di stomaco

Dopo i 50 anni il corpo di un uomo cambia inevitabilmente. In particolare, c’è una

Il benessere psicologico degli anziani incide non solo sulla qualità della loro vita, ma ha anche un ruolo protettivo in molte malattie tipiche dell’età matura.

La menopausa può essere responsabile di una pelle meno soda e luminosa.
Ecco come intervenire per rassodare la pelle e tornare a essere toniche

Una ridotta sensibilità uditiva che colpisce con l’avanzare dell’età. Conosciamo meglio che cos’è la presbiacusia e le varie opzioni terapeutiche

Che cosa si intende per drenare i liquidi? E come possiamo intervenire in modo naturale per ridurre lo spiacevole effetto a “buccia d’arancia” e, in generale, migliorare l’idratazione del nostro organismo rendendolo meno soggetto a inestetismi?

Bastano pochi accorgimenti per invertire la “rotta” alimentare
e ripristinare un approccio sano all’alimentazione per rimettersi subito in forma

Molte donne si interrogano se sia possibile o meno dopo i 60 anni, avere una

Non sempre il momento del pensionamento viene vissuto negativamente, capita spesso di guardarlo come un

Per quella legata al dimagrimento si parla piuttosto di ginnastica isometrica per addominali, gambe e glutei. Gioie e dolori dei macchinari adatti a ridefinire la massa muscolare e altri consigli utili

Su che cosa si basa, come si svolge e quali sono i suoi campi di applicazione

Rimedi per sgonfiare le palpebre

Non è facile diagnosticarlo perché può essere confuso con altri disturbi o anche solo con il naturale processo d’invecchiamento. Ecco tutto ciò che è importante sapere

Oggi il minimalismo, il cui motto è less is more, cioè meno è di più, si traduce nella ricerca di ciò che possa essere utile o che ci procuri piacere

Superati i 50 alcune persone iniziano a sentire il peso dell’età, entrando in una profonda

In che cosa consiste e come può migliorare il microcircolo e gli inestetismi della pelle

Per molti pare impossibile riuscire a perdere peso dopo una certa età. Anche se è più complicato, le soluzioni esistono a partire dal corretto tipo di allenamento fuori o dentro casa. Vediamo come riuscirci

Gli uomini sono spesso restii a occuparsi della propria salute, soprattutto quando riguarda i loro

Prevenire è meglio che diagnosticare (anche se va bene anche questo).

I benefici vanno dalla diminuzione dei livelli di stress alla maggiore ossigenazione sino all’aumentato consumo metabolico

Per contrastare i disturbi autunnali si può ricorrere a rimedi verdi e a una serie di accortezze che riguardano l’alimentazione

L’ipertrofia prostatica può portare con sé tutta una serie di disturbi. Ecco che cosa c’è da sapere

Quasi sempre questo tipo di mal di testa dipende da qualcos’altro. Andiamo a vedere da che cosa può essere causato e come intervenire

Il sesso non ha età. Ecco alcuni suggerimenti per farlo meglio.

Dopo aver capito che cosa è il colesterolo è importante conoscere i cibi che consentono di abbassarlo ma anche quelli che è bene evitare

A differenza di quanto possiamo pensare il decadimento fisico non inizia da ciò che vediamo all’esterno, ovvero rughe, capelli bianchi e primi acciacchi, bensì dalle informazioni “trasportate” sulle proteine. Ecco che cosa c’è da sapere

La salute fa riferimento ad una buona condizione fisica e psichica, il benessere invece deve essere considerato come una condizione multidimensionale.

La diminuzione di ore di luce può causare tutta una serie di disturbi.
Vediamo quali e come intervenire

Che cosa sono e che cosa è possibile fare per sopportarle meglio

Quali precauzioni mettere in atto per limitare i rischi di questa fastidiosa
e talvolta pericolosa allergia

Nella maggior parte dei casi è un disturbo che scompare da solo, ma a volte può essere sintomo di un’altra patologia o essere la causa di un disturbo. Ecco che cosa c’è da sapere

Oltre a prodotti e trattamenti, esistono dei metodi naturalissimi e a portata di mano di tutti per migliorare la pelle del viso, come la ginnastica facciale

Il sesso fa bene e continuare a farlo anche dopo i 60 anni supporta la salute

Gli studi scientifici dimostrano che lo studio di una o più lingue straniere in età avanzata protegge il cervello da demenza e Alzheimer

Un’attività che fa bene a corpo e a mente

Ecco i 10 cibi top per un buon bilanciamento tra colesterolo buono e cattivo

Il mare è un’ottima terapia per stare bene a ogni livello

I pilastri del medico svedese Markuland per una sana longevità

Gli inestetismi della pelle possono far sentire le persone a disagio, in alcuni casi arrivando

Il calo della libido femminile non è necessariamente legato all’età.
Vediamo perché

Come prevenire questa pericolosa condizione con le mosse giuste

La cataratta è uno dei problemi della vista più comuni tra la popolazione anziana: in

L’agognata estate è per molti, soprattutto per chi è già in pensione, un’ulteriore occasione di

Come ogni anno purtroppo la stagione estiva inizia anticipatamente a far sentire i suoi aspetti

Un numero sempre maggiore di studi scientifici dimostrano che può influire sullo stato di salute
Come ogni anno purtroppo la stagione estiva inizia anticipatamente a far sentire i suoi aspetti

La parola fibromialgia (FM) deriva dal latino fibra, che sta a indicare i tessuti fibrosi

La sindrome del nido vuoto ha a che fare con quella specifica condizione psicologica sviluppata

Perché è importante applicarla?

Le terme per molto tempo sono state oggetto di rappresentazione di uno status di borghesia

[pronto] La sindrome del nido vuoto ha a che fare con quella specifica condizione psicologica

Riuscire a tenere sotto controllo la pressione dopo i 60 anni è indispensabile. Avere valori

Ci risiamo: arriva l’estate e con essa il grido che l’accompagna: “Aiuto! Devo indossare il

Uno degli effetti di questa inaspettata longevità è la presenza contemporanea nelle famiglie di 5/6

La Sars-Cov-2, che ha causato il Covid- 19 ha generato una grave crisi sanitaria, ma

Nel 1949 il Mental Health America ha deciso di istituire negli Stati Uniti il mese

Sono noti a tutti i benefici delle attività in acqua, a partire dal controllo del

Quando le giornate iniziano ad allungarsi, le temperature si fanno più miti e l’aria inizia

Dormire bene è incredibilmente importante per la salute del nostro organismo. Le ore di riposo

Dopo i 60 anni mantenersi in una buona se non ottima forma fisica è possibile.

I disturbi connessi con l’avanzare dell’età (per esempio la memoria comincia a vacillare, la vista

Facciamo una premessa: praticare nuoto fa bene. A qualunque età. Rispetto ad altri sport, infatti,

Cosa succede ai nostri comunicatori di professione? Sembra che non vedano la società per come

È scientificamente provato che la meditazione a 60 anni e anche per altre classi di

Utilizziamo il regno animale per parlare delle abitudini del sonno e, nello specifico, delle differenze

Dare una definizione di autostima non è affar semplice perché essa è il frutto di

Molto invalidante, dolorosa e capace di impedire le normali attività quotidiane, la cervicalgia, chiamata comunemente

Avere una panoramica ben chiara circa la tematica artrosi antinfiammatori è di sicuro molto utile,

Ritenzione idrica e liquidi in eccesso sono due fenomeni diffusi a tutte le età, anche

Forse non tutti sanno che la perdita di massa muscolare scheletrica dovuta all’avanzare dell’età, e

L’ipertrofia prostatica benigna (IPB) o adenoma prostatico è una malattia piuttosto comune negli uomini soprattutto

Quando finisce l’inverno possono manifestarsi alcuni disturbi legati al cambio di stagione. La primavera, infatti,

Primavera, tempo di rinascita, ma per molti anche stagione di “sofferenza” in quanto accompagnata da

Almeno una volta nella vita avrete senza dubbio sentito parlare di omega 3, quasi sicuramente

Al contrario di quanto pensano tante persone, cellulite e ritenzione idrica non sono la stessa

Con l’avanzare degli anni si manifestano varie modifiche a livello posturale, che soprattutto negli anziani

Con il passare degli anni inevitabilmente l’organismo cambia. Contemporaneamente mutano anche le esigenze dal punto

Ve li ricordate i Queen, quando cantavano Who wants to live forever? Era l’epoca di

Parlare d’intolleranze alimentari è sempre una questione spinosa anche perché molti non le riconoscono e

Per molti uomini arriva prima o poi quel momento in cui loro percepiscono delle strane

Prima di capire come agire per abbassare livelli elevati di potassio nel sangue occorre fare

Qualsiasi sia l’allenamento prescelto, la pratica di una regolare attività fisica è di fondamentale importanza

La biorivitalizzazione viso è uno dei trattamenti estetici più in voga, soprattutto a fronte

Con le feste natalizie in archivio, arriva per tutti il momento di fare i conti

Che cos’è la ritenzione idrica? Ne abbiamo sentito parlare spesso e qualche volta la confondiamo

Avere la pancia piatta per le donne e per gli uomini è una questione spinosa

Rallentare. Fermarsi. Avere tempo e non avere fretta. Sembra di vivere in un mondo in

Camminare è una delle attività più sane e può essere praticata da chiunque e a

Il raggiungimento dei 60 anni deve essere visto come un momento importante per la propria

Anche se si parla del problema degli stereotipi sulla terza età, le conseguenze negative della

Ageismo è una brutta parola, primo perché malamente derivata non tradotta dall’inglese – fu coniata

Se è vero che l’età media si è allungata e che rispetto a una volta

Il piano per la riduzione delle emissioni dell’Unione Europea spinge alla pedonalizzazione delle città, evoluzione

Si può affermare con certezza che ridere fa bene alla salute. Quest’affermazione trova conferma ogni

La tiroide è una piccola ghiandola a forma di farfalla posta alla base del collo,

Iniziamo con il dire che il termine andropausa è un neologismo nato per associazione con

L’incontinenza urinaria nell’uomo è una condizione che oltre ai disagi oggettivi crea spesso una condizione soggettiva

L’incontinenza urinaria femminile è soprannominata la “malattia silenziosa”. Le sue conseguenze psicologiche sono a volte

Una vecchiaia sempre più lunga è difficile da governare, come la genitorialità che ci piomba

La demenza è una di quelle patologie con cui una società come la nostra, dove

Ci sono argomenti che spesso rappresentano un vero e proprio tabù come l’ipoacusia conosciuta più

La vitamina D è una di quelle sostanze che viene prodotta dal nostro corpo mediante

Quando si raggiungono i 50 anni è bene compiere un’attenta valutazione sulle nostre condizioni generali

Parliamoci chiaro: invecchiare fa paura. A tutti. L’unica differenza è rappresentata dal modo di manifestarlo

Per capire che cosa si intende con dieta funzionale occorre innanzitutto riflettere sul suo significato.

Molte donne guardandosi allo specchio notano cambiamenti sul viso che non è più come quello

La pasta integrale fa ingrassare? È questa la domanda che molte persone si fanno ogni

Ogni volta che si aggiunge una candelina alla torta di compleanno si è pervasi da

C’è una città in Giappone la cui giunta ha deliberato che sul suo territorio non

In moltissimi almeno qualche volta nella vita abbiamo avvertito in modo più o meno marcato

Il Tai Chi o Tai Chi Chuan è una disciplina dalle origini antiche lunga tre

La pelle è l’organo più esteso del corpo ed è anche la barriera che ci

Fare l’amore a 60 anni (e oltre) è possibile: al contrario di quello che si

Quando parliamo di Meridiani energetici alludiamo a una rete di collegamenti simmetrici tra destra e

La corsa è un’attività sportiva che apporta diversi benefici per la salute dell’organismo e che

Rispondere alla domanda “pancia gonfia: cosa mangiare?” non è un compito semplice, perché si tratta

In moltissimi almeno qualche volta nella vita abbiamo avvertito in modo più o meno marcato

Pensate all’ultima volta che il “vostro” medico di famiglia è venuto direttamente a casa vostra

Longevità e cambiamenti sempre più veloci impongono all’uomo di rivedere continuamente le proprie competenze. Si

Avere 60 anni, come abbiamo detto più e più volte, non significa dover prestare attenzione

La pressione arteriosa è uno dei valori più importanti per conoscere il vostro stato di

Se avete superato da poco la soglia dei 60 anni, molto probabilmente vi sarà già

Molte persone sono convinte che, dopo una certa età, far entrare nella propria vita un

I cani fanno bene alla salute (in realtà, anche i gatti) e non a caso

Prima di pensare a come poter intervenire cerchiamo di conoscere che cos’è l’artrite. L’artrite è

Fare esercizio fisico è un toccasana per corpo e mente. Aiuta a mantenere tonici e

Sappiamo tutti sin troppo bene che fare movimento o praticare sport sono un vero toccasana

Per le donne avere delle belle gambe da mostrare, soprattutto in estate senza calze, è

In occasione del 63° Congresso Nazionale della Società Italiana di Gerontologia e Geriatria, che si

In quest’ultimo ventennio la maggior parte di noi ha acquisito e consolidato la consapevolezza di

Per parlare di come raggiungere il benessere emotivo nella terza età è necessario innanzitutto riflettere

L’avanzare degli anni a molte persone fa paura. Entrare nella cosiddetta terza età significa dover

Da un paio di decenni il tema dell’invecchiamento è diventato di prioritario interesse in ambienti

Voglia di ritornare fra i banchi di scuola? L’Università della terza età a Milano è

Andare in pensione non significa parcheggiarsi a lato dell’autostrada della vita, quella che percorrevamo a
C’è un nemico della salute che spesso viene sottovalutato poiché non lo si conosce abbastanza,

La prevenzione delle malattie è, spesso, parte della cura stessa. È fondamentale fare periodicamente dei

La caduta dei capelli nelle donne è ancora oggi un tabù. Un argomento di cui

Cari amici di Cocooners, siamo nel pieno della bella stagione e la voglia di andare

Raggiungere i 60 anni di età, molto spesso, significa dover fare i conti con un

Prima di pensare a come agire per accelerare il metabolismo a 60 anni è importante

I consigli di Cocooners per mantenersi in forma

Se c’è un’eredità buona lasciata dall’emergenza covid-19 è stata l’esplosione prevedibile delle lezioni di ‘digital

Quanti di voi hanno sentito parlare in questi ultimi anni della dieta mima-digiuno? Questo tipo

L’ingresso nella fase della menopausa segna un punto di svolta significativo nella vita di una

Nel mondo, il termine “ageism” è piuttosto noto, mentre la sua traduzione italiana, ovvero la

I microrganismi sono “lavoratori instancabili”, motivo per cui sono impiegati nelle industrie alimentari per ottenere

Insieme a Gianmarco Tamberi, Gaudiano, Mara Navarria e Margherita Granbassi, Fondazione AIRC continua a informare i

Che cos’è la bellezza? Ma soprattutto perché sono sempre le donne a vedersi poco belle?

Un buon sonno diventa affare sempre più complicato man mano che gli anni avanzano. In

Camminare è l’attività fisica preferita dagli italiani e una disciplina aerobica tra le più efficaci,

Perdere peso non è mai affar semplice, soprattutto se non abbiamo ben presente che la

Da un punto di vista anatomico il cervello non è un muscolo eppure, se lo

Chi ha qualche chilo da smaltire o vuole tonificare i muscoli ma non è un

Con l’avanzare dell’età è fondamentale prendersi cura del proprio corpo con adeguati integratori alimentari, non

Al giorno d’oggi si parla sempre più frequentemente di meditazione anche dopo una certa età.

Con l’avanzare degli anni, una delle facoltà che si perdono e che sarebbe invece chiave

Sono numerose le ricerche scientifiche che si sono concentrate sugli effetti positivi della pratica nelle

Sono moltissime le posizioni nello yoga che lavorano sugli organi interni. Tra le più efficaci

E’ possibile prevenire e curare la sciatica con una semplice posizione che lavora sul muscolo

Tu chiamalo, se vuoi, effetto Amazon. Mai come negli ultimi mesi ci siamo abituati all’idea

Un’allergia improvvisa, una fastidiosa cefalea di cui non avevo mai sofferto, un problema con la

A tutti i membri di Cocooners una convenzione esclusiva per la propria salute Oggi purtroppo con il

Alcuni nuclei sociali si creano sulle basi di un desiderio condiviso. Come le famiglie. O

Succede ciclicamente. Con l’anno nuovo, certo, che è passato da un po’; ma anche all’arrivo

Molte persone seguono i corsi di pilates e sperimentano i benefici che derivano da essi.

Molte persone negli ultimi tempi stanno diventando vegani. Alcuni considerano questa tendenza una semplice moda

A tutti può capitare di vivere dei periodi difficili, in cui un problema di lavoro,

Sottoscrivi la convenzione e prenoti visite mediche e prestazioni specialistiche a prezzi scontati Cocooners

Perché praticare la mindfulness? I benefici della meditazione consapevole sono molteplici e, tra i vantaggi

Con le palestre chiuse e lo sport all’aperto fortemente limitato chi non vuole rinunciare all’attività

Sono sempre di più le persone che sono interessate alla possibilità di praticare yoga a

Una soluzione per Sentire e Sentirsi bene

Un’infezione batterica dei reni che può essere curata anche grazie all’ausilio di rimedi naturali.
Che cosa c’è da sapere
Abbiamo selezionato per voi una serie di incontri virtuali che oltrepassano i confini spaziali, le distanze geografiche e temporali alla scoperta di artisti.

Abbiamo selezionato per voi una serie di incontri virtuali che oltrepassano i confini spaziali, le distanze geografiche e temporali alla scoperta di artisti, monumenti, siti.

Consectetur adipiscing elit ut aliquam.

Consectetur adipiscing elit ut aliquam.

Consectetur adipiscing elit ut aliquam.

Conferma di voler bloccare questo membro.
Non sarai più in grado di:
Siete pregati di notare che: Questa azione rimuoverà anche questo membro dalle connessioni e invierà un rapporto all'amministratore del sito. Attendere alcuni minuti per il completamento di questo processo.
Ti ricontatteremo entro due giorni lavorativi
in merito al preventivo richiesto.
Se non sei ancora socio Cocooners
iscriviti subito è gratuito